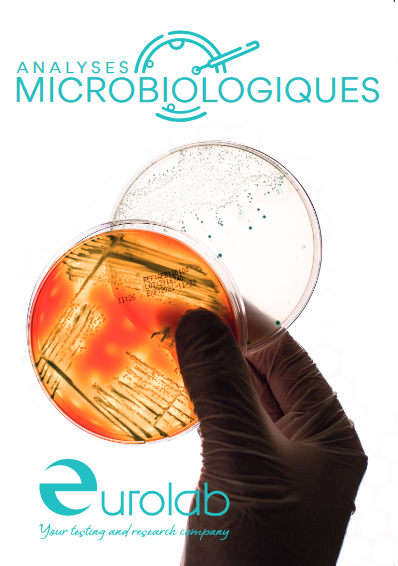

Nouvelles
-



AGRÉMENT DÉPENSES DE RECHERCHE et DÉVELOPPEMENT (CIR)
Après avoir effectué les travaux nécessaires exigés par l'État français, nous avons le plaisir de vous informer de l'approbation par le Ministère de l’Enseignement Supérieur et de la Recherche et la Innovation français de l'agrément de notre laboratoire en tant que centre de recherche et développement reconnu.
Cela permet des crédits d'impôt importants pour nos clients en France (Crédit d’Impôt Recherche) -




OBERTURE DES NOUVELLES INSTALLATIONS A MADRID
Est un plaisir de vous informer de l’ouverture de notre nouveau laboratoire à Madrid.
Centré sur la réalisation de tests microbiologiques pour le secteur de la cosmétique, ces nouvelles installations nous permettront de nous rapprocher d'un plus grand nombre de clients et d'améliorer les services que nous proposons habituellement.
Cela a été une année d'efforts depuis que nous avons décidé de faire cet investissement, et la pandémie que nous traversons ne nous a pas facilité la tâche, mais nous pouvons enfin dire avec fierté que nos nouvelles installations sont opérationnelles. -



NOUVELLES INSTALLATIONS À BARCELONE
Fin 2020, le transfert du siège du laboratoire dans ses nouveaux locaux est achevé.
Le nouveau centre est situé à quelques mètres du précédent et représente une augmentation de 50% de la surface totale.
Cela a impliqué nos services administratifs et commerciaux et les services techniques de microbiologie, chimie et toxicologie, qui y exercent leurs activités.